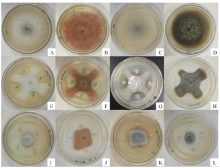

作者简介:胡进玲(1991-),女,甘肃白银人,在读硕士。E-mail: hujl15@lzu.edu.cn
本研究采用革兰氏染色、显微观察和分子生物学方法鉴定了2种具有拮抗潜力的微生物的分类地位,采用PDA培养基平板对峙法测定了其对苜蓿茎点霉( Phoma medicaginis)等9种常见的紫花苜蓿主要病原真菌的拮抗效果。研究结果表明这2种菌分别为解淀粉芽孢杆菌( Bacillus amyloliquefaciens)和卡那霉素链霉菌( Streptomyces kanamyceticus)。前者对供试病原菌的抑菌率为24.02%~71.11%,其中对苜蓿尾孢菌(71.11%)、苜蓿匍柄霉(64.76%)和粉红镰孢(60.55%)抑菌效果最强;后者对供试病原菌抑菌率为49.95%~76.90%,其中对三叶草刺盘孢(76.90%)、苜蓿茎点霉(70.94%)、苜蓿匍柄霉(68.01%)和苜蓿小光壳(60.99%)抑制效果较强。两株菌对供试苜蓿9种病原真菌均表现出不同程度的拮抗作用,该研究结果为解淀粉芽孢杆菌和卡那霉素链霉菌作为紫花苜蓿多种病害的生物防治资源以及进一步开发利用提供了理论依据。
The inhibitory effect of two bacteria on 9 alfalfa pathogens were tested on PDA medium using the confrontation method; the taxonomic status of each pathogen species were determined using morphological and molecular criteria. The bacteria identified were Bacillus amyloliquefaciens and Streptomyces kanamycin. The inhibitory effect of Bacillus amyloliquefaciens ranged from 24.02%-71.11%, with the greatest effect shown against Cercospora medicaginis (71.11%), Stemphylium botryosum (64.76%) and Fusarium roseum (60.55%). The inhibitory range of Streptomyces kanamycin was similar (49.95%-76.90%) with greatest effect against Colletotrichum trifolii (76.90%), Phoma medicaginis (70.94%), Stemphylium botryosum (68.01%) and Leptosphaerulina briosiana (60.99%). Bacillus amyloliquefaciens and Streptomyces kanamycin showed varying degrees of antagonism to different alfalfa pathogenic fungi indicate that they have promise as biological control agents for a variety of Medicago sativa foliar diseases, suggesting further development should be undertaken.
苜蓿(Medicago sativa)是全世界最重要的多年生豆科牧草, 无论其产量还是营养价值均居牧草之首, 被誉为“ 牧草之王” [1]。近几年来, 随着我国草地畜牧业的发展和农业产业结构调整, 苜蓿的种植面积进一步扩大, 而病害问题日益引起生产者的重视。据统计, 每年全世界由于病害而造成的苜蓿减产达20%以上[2], 苜蓿病害可使牧草产量大幅度减少, 牧草的营养成分降低, 适口性下降, 严重影响苜蓿的产量和饲用价值。
苜蓿为多年生豆科植物, 在大田中一次种植可多年利用[3], 因此根腐病成为危害苜蓿最严重的病害之一[4]。苜蓿根腐病可造成苜蓿产量下降和植株衰败[5], 严重时死亡率可达60.08%~73.45%, 是限制苜蓿生产的主要因素[6]。苜蓿根腐病是一种典型的土传病害, 病原种类较多, 其中来自种子、土壤和病残体的镰刀菌是重要的土传病原真菌, 其可在苗期从根部侵入, 也可在成株期从根部或直接从伤口侵入, 引起苜蓿根茎腐烂[7]。苜蓿病害是由病原真菌、细菌、病毒等多种病原物所引起的, 受害最大的部位除了根部还有叶部, 通常称为叶部病害[3]。其中, 叶斑病是引起苜蓿产量下降, 品质变劣的重要限制因素[8]。常见的苜蓿叶斑病害有茎点霉叶斑病(Phoma medicaginis), 匍柄霉叶斑病(Stemphylium botryosum)、小光壳叶斑病(Leptosphaerulina briosiana)等, 其中, 茎点霉叶斑病又称苜蓿春季黑茎病或轮纹病, 是一种世界性毁灭性病害, 2013年5月到9月对东北地区苜蓿种植区病害调查中发现此病的发病率可达40%以上, 严重发生时, 叶片提早脱落, 产量下降, 已成为苜蓿生产亟待解决的问题[2]。据调查, 苜蓿叶斑病病菌都可在苜蓿的根茎内或是病原残体上越冬, 是主要的初侵染源, 在田间主要靠气流、风和雨水传播病害, 可反复多次侵染, 是造成病害大流行的主要原因[4]。综上可知, 苜蓿的根部和叶部病害仅靠单一的化学防治或栽培措施, 难以达到期待的防治效果。
生物防治与化学防治相比具有不易使病原菌产生耐药性、对人畜安全无毒、不污染环境、无残留和具有对作物的促生作用等优点, 越来越受到人们的重视[9]。生防菌剂在一些作物上也已得到了广泛应用, 据报道哈茨木霉(Trichoderma harzianum)、绿色木霉(Trichoderma viride)分别对橡胶炭疽病菌(Colletotrichum musae)、西瓜枯萎病菌(Fusarium oxysporum f.sp.niveum)、水稻纹枯病菌(Rhizoctonia solani)、红麻灰霉病菌(Botrytis cinerea)具有较好的抑制效果[10]。恶臭假单胞杆菌(Pseudomonas putida)被用作防治棉花枯萎病(Fusarium oxysporum f. sp. vasinfectum)[11], 微生物拮抗剂被用来防治水果和蔬菜采摘后的病害[12]。采用生物防治控制牧草病害, 虽然距商业化还有一定距离[13, 14], 但也取得了一些进展[15, 16]。然而生防在苜蓿方面的研究、应用甚少。因此, 本试验使用从紫花苜蓿根组织中分离的2种微生物, 以引起苜蓿根腐病、叶斑病、炭疽病等几种主要病原菌为供试菌, 筛选具有广谱抑菌活性的拮抗菌株, 通过形态学和16s rDNA基因序列分析等手段对菌株进行分类鉴定, 以期为苜蓿生防菌资源的深入研究和开发提供科学依据。
营养琼脂培养基(NA)、马铃薯葡萄糖琼脂培养基(PDA)[17]。试验时间:2016年1月9日至1月20日。
1.2.1 拮抗菌株及来源 待测拮抗菌为LYZ0069和LYZ0133, 分离自紫花苜蓿根部。
1.2.2 供试病原菌及来源 供试病原真菌为如下9种:苜蓿茎点霉、苜蓿小光壳、三叶草刺盘孢(Colletotrichum trifolii)、苜蓿匍柄霉、苜蓿尾孢菌(Cercospora medicaginis)、尖镰孢(Fusarium oxysporium)、粉红镰孢(Fusarium roseum)、腐皮镰刀菌(Fusarium solani)和苜蓿壳针孢(Septoria medicaginis), 均由本实验室从染病的紫花苜蓿植株上分离, 经形态学和分子生物学方法准确鉴定到种, 保存于本实验室。
1.3.1 培养特征鉴定 根据细菌形态特征鉴定方法对本研究的拮抗菌进行鉴定[18]。仔细观察生长于牛肉膏蛋白胨平板上的细菌的菌落形态, 划单菌落鉴定其群体形态特征。
1.3.2 革兰氏染色 将细菌在28 ℃下培养24~48 h之后进行革兰氏染色, 挑取少量细菌于滴有蒸馏水的载玻片上混合, 通过火焰3次固定。加上结晶紫后染色1 min, 水洗; 加上碘液后染色1 min, 水洗。加上95%酒精, 摇动玻片, 脱色20~60 s, 水洗, 吸取水分; 加上蕃红后, 染色1 min, 水洗。吸干或在空气中晾干后, 油镜镜检。通过革兰氏染色观察其个体形态特征[17]。
1.3.3 芽孢染色 同样, 将细菌在28 ℃下培养24~48 h之后用于芽孢染色, 首先固定细菌于载玻片上, 加数滴5%孔雀绿染液于涂片上, 在微火上加热至燃料冒蒸汽并开始计时, 维持5 min, 加热过程中及时补充染液, 切勿让涂片干涸; 待玻片冷却后, 用环流自来水冲洗载玻片, 直至流出的水无色为止; 用0.5%蕃红染液复染1.5 min, 用缓流水洗后干燥, 油镜镜检。通过芽孢染色观察细菌产孢情况及芽孢形态特征[17]。
1.3.4 分子鉴定 细菌的全基因组使用OMEGA Bacterial DNA Kit试剂盒进行提取。PCR扩增采用细菌通物1429R:5'-GAGAGTTTGATCCTGGCTCAG-3'和27F:5'-CTACGGCTACCTTGTTACGA-3', 由上海生工生物公司合成。PCR扩增反应体系为20 μ L:基因组DNA 0.5 μ L、ddH2O 8.5 μ L、mix 10 μ L、引物1429R 0.5 μ L和27F 0.5 μ L。PCR扩增条件:95 ℃预变性3 min; 95 ℃变性30 s, 50 ℃退火30 s, 72 ℃延伸60 s, 循环30次; 72 ℃再延伸10 min。PCR产物经1%琼脂糖凝胶电泳检测后送上海生工生物公司测序。用NCBI数据库中的BLAST软件将测序得到的序列和GenBank中的核酸序列进行比对分析, 寻找与目的序列同源性高且通过正式发表的菌株用于系统发育分析, 再用ClustaL X对其进行多重比对, 之后采用MEGA6软件以邻接法(neighbor-joining, NJ)构建系统发育树。设置1000次随机抽样, 计算自引导值(bootstrap), 以评估系统发育树的置信度[19]。
采用PDA平板对峙法测定细菌的抑菌作用[20]。在平板(90 mm)中央分别点病原真菌(直径=5 mm)为指示菌, 将待测拮抗菌株呈“ +” 字涂点于菌饼周围4点, 各点距离指示菌2 cm, 以只接种病原菌的平板为对照, 待对照菌落长满平板时, 利用游标卡尺测量抑菌圈和菌落的生长直径。按下式计算菌落的生长抑制率:
菌落生长抑制率=
形态学观察结果显示, 菌株LYZ0069于28 ℃培养24 h, 菌落在牛肉膏蛋白胨培养基上呈乳白色, 中心隆起, 边缘整齐, 菌落圆形或椭圆, 湿润、半透明, 培养72 h后菌落表面变得干燥, 起皱, 革兰氏染色G+镜检呈杆状, 约1.95 μ m, 芽孢染色显示产芽孢且芽孢呈椭圆到柱状, 位于菌体中央或稍偏。鉴定结果表示, 菌株LYZ0069具有典型的芽孢杆菌的特征。菌株LYZ0133菌落小而致密、干而不透明, 24 h时表面光滑、边缘整齐、颜色单调、不易挑起, 继而发展成褶皱状。菌落生长缓慢, 革兰氏染色G+(图1)。
经测序, 菌株LYZ0069和LYZ0133的16S rDNA序列长度为1445和1420 bp, 提交GenBank进行比对, 结果与LYZ0069同源性最高的为解淀粉芽孢杆菌(Bacillus amyloliquefaciens, 登录号为:JN700127.1和JN700124.1), 其同源性为100%; 与LYZ0133同源性最高的为卡那霉素链霉菌(Streptomyces kanamyceticus, 登录号:NR_112397.1)。
根据构建的系统发育树, 我们发现拮抗菌LYZ0069与解淀粉芽孢杆菌(Bacillus amyloliquefaciens, 登录号为:JN700127.1、JN700124.1)聚为一簇; LYZ0133与卡那霉素链霉菌(Streptomyces kanamyceticus, 登录号:NR_112397.1)聚为一支, 而且支持率都在99%以上。通过对拮抗菌LYZ0069和LYZ0133的16 srDNA基因全序列分析, 与GenBank中收录的细菌基因序列比对, 结合形态学鉴定得到LYZ0069为解淀粉芽孢杆菌, LYZ0133为卡那霉素链霉菌(图2)。
抑菌试验结果表明, 解淀粉芽孢杆菌对供试9种苜蓿病原真菌中的8种病原菌有拮抗作用, 且对其中7种病原菌抑菌率显著(> 50%), 按其抑菌率由大到小排序为:苜蓿小光壳 (71.11%)> 苜蓿匍柄霉(64.76%)> 三叶草刺盘孢 (60.55%)> 粉红镰孢 (58.90%)> 腐皮镰刀菌(57.71%)> 尖镰孢 (54.23%)> 苜蓿茎点霉 (53.15%)> 苜蓿尾孢菌 (24.02%); 卡那霉素链霉菌对其中7种病原真菌有拮抗作用, 抑菌效果显著的有6种, 按其抑菌率由大到小顺序为: 三叶草刺盘孢 (76.90%)> 苜蓿茎点霉(70.94%)> 苜蓿匍柄霉(68.01%)> 苜蓿小光壳(60.99%)> 腐皮镰刀菌(56.20%)> 尖镰孢 (56.11%)> 粉红镰孢(49.95%)。另外, 通过对两种拮抗菌的拮抗作用比较, 我们发现两种拮抗菌对其中7种病原真菌同时表现出拮抗作用, 但解淀粉芽孢杆菌对苜蓿小光壳、腐皮镰刀菌和粉红镰孢的抑菌效果均强于卡那霉素链霉菌; 卡那霉素链霉菌对苜蓿茎点霉、三叶草刺盘孢、苜蓿匍柄霉和尖镰孢的抑制作用强于解淀粉芽孢杆菌(表1)。从其拮抗效果上可以看出两种拮抗菌与病原真菌均未发生物理接触而起作用, 且解淀粉芽孢杆菌主要抑制其周围的细菌生长, 而卡那霉素链霉菌可以显著抑制整个病原真菌的生长繁殖(图3)。
| 表1 解淀粉芽孢杆菌和卡那链霉菌对紫花苜蓿病原菌的抑菌率 Table 1 The antagonistic inhibitory rate of Bacillus amyloliquefaciens and Streptomyces kanamyceticus against Medicago sativa fungal pathogens |
近年来, 随着我国草地畜牧业的发展和农业产业结构调整, 紫花苜蓿种植面积持续增加, 病害问题也日趋严重, 但是由于草地本身的特点及经济、环境和食品安全等因素, 化学农药的应用受到严重制约[10]。因此寻找经济、环境友好型的生物防治资源迫在眉睫[14]。在紫花苜蓿病害病原真菌的分离培养过程中, 我们发现有2种微生物表现出明显的抑菌效果, 经形态学和16s rDNA等技术手段的综合鉴定, 确定两株拮抗菌分别为解淀粉芽孢杆菌和卡那霉素链霉菌。为确定该两种具有生防潜力的菌株对紫花苜蓿病害主要病原真菌的拮抗作用, 本研究用这两种菌通过平板对峙法对导致苜蓿根腐病等根部病害及叶斑病、炭疽病等叶部茎部病害的9种主要的病原真菌进行室内拮抗试验, 两种拮抗菌均表现出较强的拮抗效果和广谱抑菌性。目前国内外应用芽孢杆菌防治植物病害非常广泛, 并已开发成多种生物菌剂而广泛应用[21, 22, 23], 解淀粉芽孢杆菌作为芽孢杆菌属较常见的一类, 用以防治多种作物病害的生防菌源, 已被开发成多种生物菌剂而广泛应用。据报道, 解淀粉芽孢杆菌对山茶灰斑病菌(Pestalotiopsis guepini)、菜心炭疽病菌(Colletotrichum higginsianum)及引起大花惠兰根腐病的尖孢镰刀菌(Fusarium oxysporium)均具有较好的拮抗作用[24, 25, 26], 而本研究中, 解淀粉芽孢杆菌对引起苜蓿叶斑病、根腐病及苜蓿炭疽病的多种病原菌均表现出良好拮抗作用, 进一步证明了解淀粉芽孢杆菌是一种具有广谱抑菌活性的细菌[27]。关于链霉菌用于生防的报道也较多, 如Shimizu等[28]发现链霉菌MBCu-56对黄瓜(Cucumis sativus)幼叶预处理浓度为109 CFU/mL时, 对黄瓜炭疽病(Colletotrichum orbiculare)表现出93%的抑制性; Yuan等[29]研究证明迪利链霉菌(Streptomyces lydicus) 对立枯丝核菌(Rhizoctonia solani)和终极腐霉(Pythium ultimum)等根部病原真菌表现出明显的抑制作用, 用其做种子包衣可减少60%的病原侵染, 在本研究中首次发现了卡那霉素链霉菌对苜蓿炭疽病菌(70.94%)及粉红镰孢(76.90%)、尖镰孢(49.95%)等苜蓿根腐病菌均表现出良好拮抗效果, 表明链霉菌具有控制炭疽病及根部病害等多种病害的巨大潜力。理想的生防菌不仅要求拮抗能力强, 而且要求生存能力强[4], 芽孢杆菌通常可忍受各种不良的环境, 能在热、紫外线、电离辐射和一些化学药品等逆境胁迫下产生具有很强抗性的芽孢, 以便于在不利环境中存活、定殖与繁殖[30, 31, 32, 33], 且具有较强的次生代谢产物和抑菌物质的产生能力[27]; 而链霉菌是高等放线菌, 可产生多种抗生素、植物激素等活性物质, 对提高植物的抗病、抗逆性能具有重要的作用, 该两种菌均具有开发成生防制剂的巨大潜力[34, 35]。在本研究中我们观察到, 两种拮抗菌与病原真菌都未发生物理接触而起作用, 结合以上讨论和有关报道[36, 37]我们推测, 主要原因是两种拮抗菌均是通过产生某种抗生素或次生代谢产物来起作用。生物防治在牧草病害上也取得了一些进展, 如蜡状芽孢杆菌(Bacillus cereus)可用于苜蓿幼苗立枯病(Rhinzoctonia leguminicola)的生物防治[15], 链霉菌可用于防治真菌造成的紫花苜蓿幼苗猝倒[16]。关于解淀粉芽孢杆菌与链霉菌在生防方面的报道多数只针对单一病害, 本研究通过对峙试验证明解淀粉芽孢杆菌和卡那霉素链霉菌对紫花苜蓿叶斑病、根腐病和炭疽病的主要病原菌均表现良好的拮抗效果, 说明其在牧草病害上有很大的生防应用潜能, 关于这两种拮抗菌的拮抗机理、室内及其大田仿效等问题还有待于进一步研究。
The authors have declared that no competing interests exist.
| [1] |
|
| [2] |
|
| [3] |
|
| [4] |
|
| [5] |
|
| [6] |
|
| [7] |
|
| [8] |
|
| [9] |
|
| [10] |
|
| [11] |
|
| [12] |
|
| [13] |
|
| [14] |
|
| [15] |
|
| [16] |
|
| [17] |
|
| [18] |
|
| [19] |
|
| [20] |
|
| [21] |
|
| [22] |
|
| [23] |
|
| [24] |
|
| [25] |
|
| [26] |
|
| [27] |
|
| [28] |
|
| [29] |
|
| [30] |
|
| [31] |
|
| [32] |
|
| [33] |
|
| [34] |
|
| [35] |
|
| [36] |
|
| [37] |
|